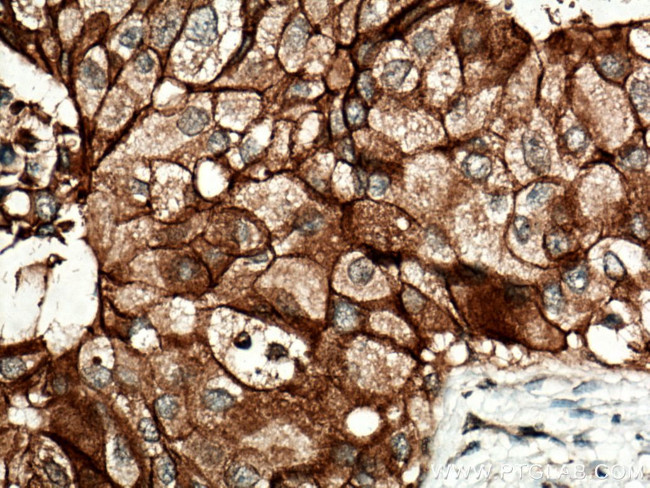
FXYD3 Antibody in Immunohistochemistry (Paraffin) (IHC (P))

Search
Proteintech
FXYD3 Polyclonal Antibody
{{$productOrderCtrl.translations['antibody.pdp.commerceCard.promotion.promotions']}}
{{$productOrderCtrl.translations['antibody.pdp.commerceCard.promotion.viewpromo']}}
{{$productOrderCtrl.translations['antibody.pdp.commerceCard.promotion.promocode']}}: {{promo.promoCode}} {{promo.promoTitle}} {{promo.promoDescription}}. {{$productOrderCtrl.translations['antibody.pdp.commerceCard.promotion.learnmore']}}
产品信息
15853-1-AP
种属反应
宿主/亚型
分类
类型
抗原
偶联物
形式
浓度
规格
纯化类型
保存液
内含物
保存条件
运输条件
产品详细信息
Immunogen sequence: MQKVTLGLL VFLAGFPVLD ANDLEDKNSP FYYDWHSLQV GGLICAGVLC AMGIIIVMSA KCKCKFGQKS GHHPGETPPL ITPGSAQS (1-87 aa encoded by BC005238)
靶标信息
FXYD3 belongs to a small family of FXYD-domain containing regulators of Na+/K+ ATPases which share a 35-amino acid signature sequence domain, beginning with the sequence PFXYD, and containing 7 invariant and 6 highly conserved amino acids. This gene encodes a cell membrane protein that may regulate the function of ion-pumps and ion-channels. This gene may also play a role in tumor progression. Alternative splicing results in multiple transcript variants encoding distinct isoforms.
仅用于科研。不用于诊断过程。未经明确授权不得转售。
篇参考文献 (0)
生物信息学
蛋白别名: Chloride conductance inducer protein Mat-8; FXYD domain-containing ion transport regulator 3; FXYD3; Mammary tumor 8 kDa protein; nmc; Phospholemman-like; phospholemman-like protein; Sodium Potassium ATPase; Sodium/potassium-transporting ATPase subunit FXYD3
基因别名: FXYD3; MAT8; PLML
UniProt ID: (Human) Q14802, (Mouse) Q61835, (Rat) P59645
Entrez Gene ID: (Human) 5349, (Mouse) 17178, (Rat) 116831